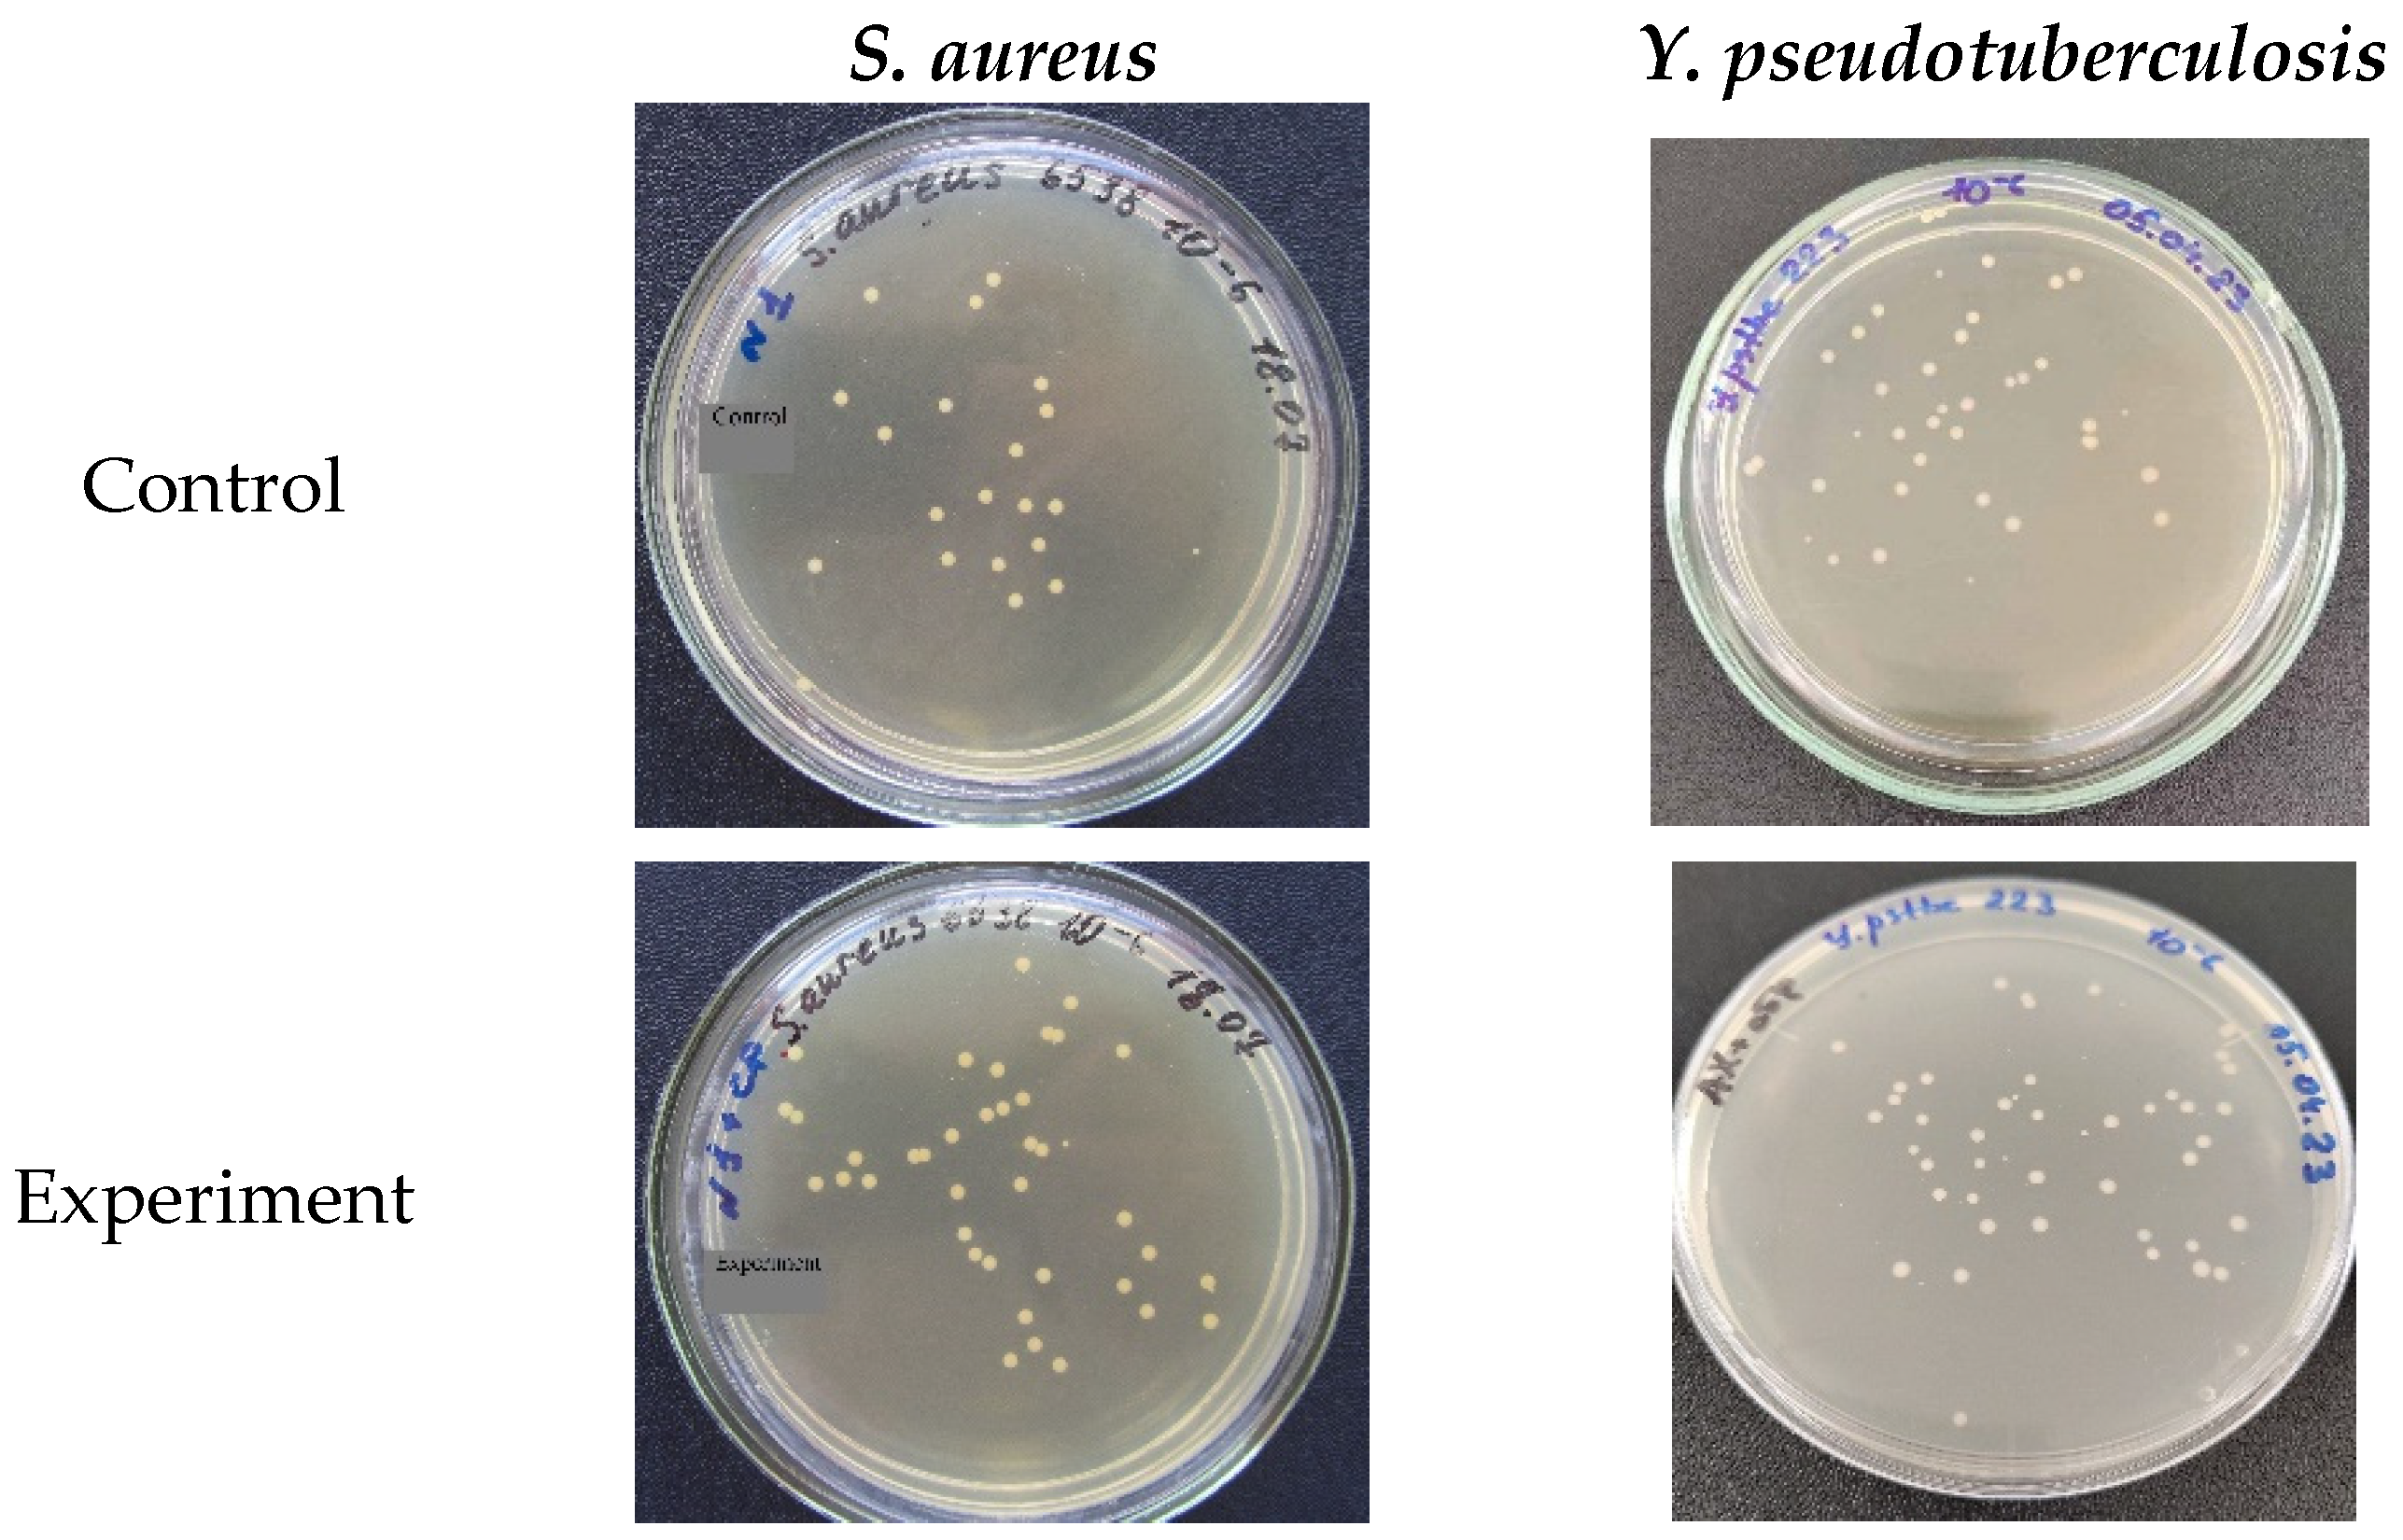
Ijms 24 09965 g004

New 3-Aminopropylsilatrane Derivatives: Synthesis, Structure, Properties, and Biological Activity
Abstract
1. Introduction
- (1)
- The aza-Michael reaction of 3-aminopropylsilatrane (1) with various alkenes;
- (2)
- The synthesis and characterization of new 3-aminopropylsilatrane derivatives using IR and NMR spectroscopy and mass and X-ray spectrometry;
- (3)
- An in silico investigation of their physical–chemical/pharmacokinetic properties, as well as in vitro evaluations of the inhibitory/stimulating effects on the Gram-positive and Gram-negative pathogenic microorganisms Listeria, Staphylococcus, and Yersinia.
2. Results and Discussions
2.1. Synthesis
2.2. Spectroscopic and Spectrometric Studies
2.2.1. IR Spectroscopy
2.2.2. NMR Spectroscopy
2.2.3. Mass Spectrometry
2.2.4. X-ray Spectrometry
2.3. Study of Biological Activity
2.3.1. In Silico Evaluation of Physicochemical and Pharmacokinetic Properties as Well as Pharmacological Activity
2.3.2. Study of the Inhibitory/Stimulating Effect on Microorganisms In Vitro
3. Materials and Methods
3.1. Chemistry
3.1.1. Silatrane 2a
3.1.2. Silatrane 2b
3.1.3. Silatrane 3a
3.1.4. Silatrane 3b
3.1.5. Silatrane 4a
3.1.6. Silatrane 4b
3.1.7. Silatrane 5a
3.1.8. Silatrane 5b
3.1.9. Silatrane 6a
3.1.10. Silatrane 6b
3.1.11. Silatrane 7a
3.2. Biology
Bacterial Strains; Microbiology Testing
4. Conclusions
Author Contributions
Funding
Institutional Review Board Statement
Informed Consent Statement
Data Availability Statement
Acknowledgments
Conflicts of Interest
References
- Franz, A.K.; Wilson, S.O. Organosilicon molecules with medicinal applications. J. Med. Chem. 2013, 56, 388–405. [Google Scholar] [CrossRef] [PubMed]
- Fujii, S.; Hashimoto, Y. Progress in the medicinal chemistry of silicon: C/Si exchange and beyond. Future Med. Chem. 2017, 9, 485–505. [Google Scholar] [CrossRef] [PubMed]
- Ramesh, R.; Reddy, D.S. Quest for Novel Chemical Entities through Incorporation of Silicon in Drug Scaffolds. J. Med. Chem. 2018, 61, 3779–3798. [Google Scholar] [CrossRef] [PubMed]
- Lazareva, N.F.; Lazarev, I.M. Drug design based on the carbon/silicon switch strategy. Russ. Chem. Bull. 2015, 64, 1221–1232. [Google Scholar] [CrossRef]
- Panayides, J.-L.; Mathieu, V.; Banuls, L.M.Y.; Apostolellis, H.; Dahan-Farkas, N.; Davids, H.; Harmse, L.; Rey, M.E.C.; Green, I.R.; Pelly, S.C.; et al. Synthesis and in vitro growth inhibitory activity of novel silyl- and tritylmodified nucleosides. Bioorg. Med. Chem. 2016, 24, 2716–2724. [Google Scholar] [CrossRef] [PubMed]
- Perestelo, N.R.; Llanos, G.G.; Reyes, C.P.; Amesty, A.; Sooda, K.; Afshinjavid, S.; Jiménez, I.A.; Javid, F.; Bazzocchi, I.L. Expanding the Chemical Space of Withaferin A by Incorporating Silicon to Improve Its Clinical Potential on Human Ovarian Carcinoma Cells. J. Med. Chem. 2019, 62, 4571–4585. [Google Scholar] [CrossRef]
- Kleemiss, F.; Justies, A.; Duvinage, D.; Watermann, P.; Ehrke, E.; Sugimoto, K.; Fugel, M.; Malaspina, L.A.; Dittmer, A.; Kleemiss, T.; et al. Sila-Ibuprofen. J. Med. Chem. 2020, 63, 12614–12622. [Google Scholar] [CrossRef]
- Fanelli, R.; Chastel, A.; Previti, S.; Hindié, E.; Vimont, D.; Zanotti-Fregonara, P.; Fernandez, P.; Garrigue, P.; Lamare, F.; Schollhammer, R.; et al. Silicon-Containing Neurotensin Analogues as Radiopharmaceuticals for NTS1-Positive Tumors Imaging. Bioconjugate Chem. 2020, 31, 2339–2349. [Google Scholar] [CrossRef]
- Liu, B.; Gai, K.; Qin, H.; Wang, J.; Liu, X.; Cao, Y.; Lu, Q.; Lu, D.; Chen, D.; Shen, H.; et al. Discovery of a Silicon-Containing Pan-Genotype Hepatitis C Virus NS5A Inhibitor. J. Med. Chem. 2020, 63, 5312–5323. [Google Scholar] [CrossRef]
- Kulkarni, A.S.; Ramesh, R.; Walia, S.; Sayyad, S.I.; Gathalkar, G.B.; Balamkundu, S.; Joshi, M.; Sen, A.; Reddy, D.S. Identification of a Novel Series of Potent Organosilicon Mosquito Repellents. ACS Omega 2021, 6, 31236–31243. [Google Scholar] [CrossRef]
- Wei, G.; Huang, M.-W.; Wang, W.-J.; Wu, Y.; Mei, S.-F.; Zhou, L.-M.; Mei, L.-C.; Zhu, X.-L.; Yang, G.-F. Expanding the Chemical Space of Succinate Dehydrogenase Inhibitors via the Carbon–Silicon Switch Strategy. J. Agricult. Food Chem. 2021, 69, 3965–3971. [Google Scholar] [CrossRef] [PubMed]
- Zhou, C.; Wang, X.; Quan, X.; Cheng, J.; Li, Z.; Maienfisch, P. Silicon-Containing Complex II Acaricides─Design, Synthesis, and Pharmacological Optimization. J. Agricult. Food Chem. 2022, 70, 11063–11074. [Google Scholar] [CrossRef] [PubMed]
- Kobayashi, T.; Nishino, S.; Miura, M.; Hirano, K. Synthesis of β-Silyl-α-amino Acid Derivatives by Cu-Catalyzed Regio- and Enantioselective Silylamination of α,β-Unsaturated Esters. Org. Lett. 2022, 24, 14181422. [Google Scholar] [CrossRef]
- El-Hussieny, M.; Mansour, S.T.; Hashem, A.I.; Fouad, M.A.; Abd-El-Maksoud, M.A. Design, synthesis, and biological evaluation of new heterocycles bearing both silicon and phosphorus as potent MMP-2 inhibitors. J. Chin. Chem. Soc. 2022, 69, 1908–1923. [Google Scholar] [CrossRef]
- Kitel, R.; Byczek-Wyrostek, A.; Hopko, K.; Kasprzycka, A.; Walczak, K. Effect of Selected Silyl Groups on the Anticancer Activity of 3,4-Dibromo-5-Hydroxy-Furan-2(5H)-One Derivatives. Pharmaceuticals 2021, 14, 1079. [Google Scholar] [CrossRef]
- Liu, T.; Yang, M.; He, J.; Li, S.; Zhang, Y. Direct synthesis of sila-benzoazoles through hydrosilylation and rearrangement cascade reaction of benzoazoles and silanes. Nat. Commun. 2023, 14, 703. [Google Scholar] [CrossRef]
- Voronkov, M.G.; Zelchan, G.I.; Lukevits, E.Y. Kreminii i zhizn’. Biokhimiya, farmakologiya i toksikologia soedinenii kremniya. In Silicon and Life. Biochemistry, Pharmacology, and Toxicology of Silicon Compounds; Zinatne: Riga, Latvia, 1978; 587p. (In Russian) [Google Scholar]
- Frampton, M.B.; Zelisko, P.M. Organosilicon Biotechnology. Silicon 2009, 1, 147–163. [Google Scholar] [CrossRef]
- Pestunovich, V.; Kirpichenko, S.; Voronkov, M. Silatranes and their tricyclic analogs. Chem. Org. Silicon Compd. 1998, 2, 1447–1537. [Google Scholar] [CrossRef]
- Voronkov, M.G.; Baryshok, V.P. Atranes As a New Generation of Biologically Active Substances. Her. Russ. Acad. Sci. 2010, 80, 514–521. [Google Scholar] [CrossRef]
- Puri, J.K.; Singh, R.; Chanal, V.K. Silatranes: A review on their synthesis, structure, reactivity and applications. Chem. Soc. Rev. 2011, 40, 1791–1840. [Google Scholar] [CrossRef]
- Voronkov, M.G.; Belyaeva, V.V.; Abzaeva, K.A. Basicity of silatranes (Review). Chem. Heterocycl. Comp. 2012, 47, 1330–1338. [Google Scholar] [CrossRef]
- Adamovich, S.N. New atranes and similar ionic complexes. Synthesis, structure, properties. Appl. Organomet. Chem. 2019, 33, e4940. [Google Scholar] [CrossRef]
- Dumitriu, A.-M.-C.; Cazacu, M.; Shova, S.; Turta, C.; Simionescu, B.C. Synthesis and structural characterization of 1-(3-aminopropyl)silatrane and some new derivatives. Polyhedron 2012, 33, 119–126. [Google Scholar] [CrossRef]
- Adamovich, S.N.; Oborina, E.N.; Nalibayeva, A.M.; Rozentsveig, I.B. 3-Aminopropylsilatrane and Its Derivatives: A Variety of Applications. Molecules 2022, 27, 3549. [Google Scholar] [CrossRef]
- Zaltariov, M.-F.; Turtoi, M.; Peptanariu, D.; Macsim, A.-M.; Clima, L.; Cojocaru, C.; Vornicu, N.; Ciubotaru, B.-I.; Bargan, A.; Calin, M.; et al. Chemical Attachment of 5-Nitrosalicylaldimine Motif to Silatrane Resulting in an Organic–Inorganic Structure with High Medicinal Significance. Pharmaceutics 2022, 14, 2838. [Google Scholar] [CrossRef]
- Viegas, C., Jr.; Danuello, A.; da Silva Bolzani, V.; Barreiro, E.J.; Fraga, C.A.M. Molecular Hybridization: A Useful Tool in the Design of New Drug Prototypes. Curr. Med. Chem. 2007, 14, 1829–1852. [Google Scholar] [CrossRef]
- Ivasiv, V.; Albertini, C.; Goncalves, A.E.; Rossi, M.; Bolognesi, M.L. Molecular Hybridization as a Tool for Designing Multitarget Drug Candidates for Complex Diseases. Curr. Top. Med. Chem. 2019, 19, 1694–1711. [Google Scholar] [CrossRef]
- Shang, H.; Li, L.; Ma, L.; Tian, Y.; Jia, H.; Zhang, T.; Yu, M.; Zou, Z. Design and Synthesis of Molecular Hybrids of Sophora Alkaloids and Cinnamic Acids as Potential Antitumor Agents. Molecules 2020, 25, 1168. [Google Scholar] [CrossRef]
- Ebenezer, O.; Singh-Pillay, A.; Koorbanally, N.A.; Singh, P. Antibacterial evaluation and molecular docking studies of pyrazole–thiosemicarbazones and their pyrazole–thiazolidinone conjugates. Mol. Divers. 2021, 25, 191–204. [Google Scholar] [CrossRef]
- Adamovich, S.N.; Kondrashov, E.V.; Ushakov, I.A.; Shatokhina, N.S.; Oborina, E.N.; Vashchenko, A.V.; Belovezhets, L.A.; Rozentsveig, I.B.; Verpoort, F. Isoxazole derivatives of silatrane: Synthesis, characterization, in silico ADME profile, prediction of potential pharmacological activity and evaluation of antimicrobial action. Appl. Organomet. Chem. 2020, 34, e5976. [Google Scholar] [CrossRef]
- Adamovich, S.N.; Sadykov, E.K.; Ushakov, I.A.; Oborina, E.N.; Belovezhets, L.A. Antibacterial activity of new silatrane pyrrole-2-carboxamide hybrids. Mendeleev Commun. 2021, 31, 204–206. [Google Scholar] [CrossRef]
- Adamovich, S.N.; Ushakov, I.A.; Oborina, E.N.; Vashchenko, A.V. Silatrane-sulfonamide hybrids: Synthesis, characterization, and evaluation of biological activity. J. Organomet. Chem. 2022, 957, 122150. [Google Scholar] [CrossRef]
- Adamovich, S.N.; Ushakov, I.A.; Oborina, E.N.; Vashchenko, A.V.; Rozentsveig, I.B.; Verpoort, F. Synthesis, structure and biological activity of hydrometallatranes. J. Mol. Liquids 2022, 358, 119213. [Google Scholar] [CrossRef]
- Singh, G.; Singh, A.; Singh, J.; Aulakh, D.; Wriedt, M.; Espinosa, C.; Esteban, M.A.; Sehgal, R.; Goyal, K.; Sinha, S. First synthesis of pyrene-functionalized silatranes for mechanistic insights into their potential anti-parasitic and anti-oxidation activities. New J. Chem. 2017, 41, 15165–15172. [Google Scholar] [CrossRef]
- Singh, G.; Arora, A.; Mangat, S.S.; Rani, S.; Kaur, H.; Goyal, K.; Sehgal, R.; Maurya, I.K.; Tewari, R.; Choquesillo-Lazarte, D.; et al. Design, synthesis and biological evaluation of chalconyl blended triazole allied organosilatranes as giardicidal and trichomonacidal agents. Eur. J. Med. Chem. 2016, 108, 287–300. [Google Scholar] [CrossRef]
- Singh, G.; Arora, A.; Kalra, P.; Maurya, I.K.; Ruizc, C.E.; Estebanc, M.A.; Sinha, S.; Goyal, K.; Sehgal, R. A strategic approach to the synthesis of ferrocene appended chalcone linked triazole allied organosilatranes: Antibacterial, antifungal, antiparasitic and antioxidant studies. Bioorg. Med. Chem. 2019, 27, 188–195. [Google Scholar] [CrossRef] [PubMed]
- Lee, T.-J.; Chau, L.-K.; Huang, C.-J. Controlled Silanization: High Molecular Regularity of Functional Thiol Groups on Siloxane Coatings. Langmuir 2020, 36, 5935–5943. [Google Scholar] [CrossRef]
- Geibel, C.; Theiner, J.; Wolter, M.; Kramer, M.; Lindner, W.; Lämmerhofer, M. Controllable organosilane monolayer density of surface bonding using silatranes for thiol functionalization of silica particles for liquid chromatography and validation of microanalytical method for elemental composition determination. J. Chromatogr. A. 2021, 1653, 46241. [Google Scholar] [CrossRef]
- Troiano, J.L.; Crabtree, R.H.; Gary, W.; Brudvig, G.W. Optimization of Surface Loading of the Silatrane Anchoring Group on TiO2. ACS Appl. Mater. Interfaces 2022, 14, 6582–6589. [Google Scholar] [CrossRef]
- Rulev, A.Y. Aza-Michael reaction: Achievements and prospects. Russ. Chem. Rev. 2011, 80, 197–219. [Google Scholar] [CrossRef]
- Sanchez-Rosello, M.; Acena, J.L.; Simon-Fuentes, A.; del Pozo, C. A general overview of the organocatalytic intramolecular aza-Michael reaction. Chem. Soc. Rev. 2014, 43, 7430–7453. [Google Scholar] [CrossRef]
- Beletskaya, I.P.; Najera, C.; Yus, M. Catalysis and regioselectivity in hydrofunctionalization reactions of unsaturated carbon bonds. Part II. Hydroamination. Russ. Chem. Rev. 2020, 89, 1074–1114. [Google Scholar] [CrossRef]
- Genest, A.; Portinha, D.; Fleury, E.; Ganachaud, F. The aza-Michael reaction as an alternative strategy to generate advanced silicon-based (macro)molecules and materials. Progress Polymer Sci. 2017, 72, 61–110. [Google Scholar] [CrossRef]
- Feng, L.; Zhu, S.; Zhang, W.; Mei, K.; Wang, H.; Feng, S. Preparation and Characterization of Functional Alkoxysilanes via Catalyst-Free Aza-Michael Reaction. ChemistrySelect 2017, 2, 3721–3724. [Google Scholar] [CrossRef]
- Singh, G.; Saroa, A.; Tewari, R.; Kaur, P. Aza-Michael Addition of γ-Aminopropylsilatranes to Substituted N-Phenylmaleimides: Design and Synthesis of a Heterocyclic Amine Receptor and Their Preliminary Antimicrobial Studies. Silicon 2017, 9, 495–501. [Google Scholar] [CrossRef]
- Lipinski, C.A.; Lombardo, F.; Dominy, B.W.; Feeney, P.J. Experimental and computational approaches to estimate solubility and permeability in drug discovery and development settings. Adv. Drug Deliv. Rev. 2001, 46, 3–26. [Google Scholar] [CrossRef] [PubMed]
- Prediction of Activity Spectra for Substances. Available online: http://www.pharmaexpert.ru/PASSOnline/ (accessed on 20 April 2023).
- Poroikov, V.V.; Filimonov, D.A.; Gloriozova, T.A.; Lagunin, A.A.; Druzhilovskiy, D.S.; Rudik, A.V.; Stolbov, L.A.; Dmitriev, A.V.; Tarasova, O.A.; Ivanov, S.M.; et al. Computer-aided prediction of biological activity spectra for organic compounds: The possibilities and limitations. Russ. Chem. Bull. 2019, 68, 2143–2154. [Google Scholar] [CrossRef]
- Kowalska-Krochmal, B.; Dudek-Wicher, R. The minimum inhibitory concentration of antibiotics: Methods, interpretation, clinical relevance. Pathogens 2021, 10, 165. [Google Scholar] [CrossRef]
- Sheldrick, G.M. Crystal structure refinement with SHELXL. Acta Cryst. Sect. C Struct. Chem. 2015, 71, 3–8. [Google Scholar] [CrossRef]
- Sheldrick, G.M. A short history of SHELX. Acta Cryst. 2008, 64, 112–122. [Google Scholar] [CrossRef]

| Entry | Ratio 1/AN | Solvent | Temp. (°C) | Time (h) | Yield 2a (%) * | Yield 2b (%) * |
|---|---|---|---|---|---|---|
| 1 | 1/1 | CHCl3 | 20 | 10 | 25 | - |
| 2 | 1/1 | MeCN | 25 | 5 | 10 | - |
| 3 | 1/1 | THF | 30 | 5 | 10 | - |
| 4 | 1/1 | MeOH | 30 | 5 | 45 | - |
| 5 | 1/1 | EtOH | 30 | 5 | 35 | - |
| 6 | 1/1 | EtOH | 50 | 5 | 65 | - |
| 7 | 1/1 | MeOH | 50 | 2 | 99 | - |
| 8 | 1/2 | MeOH | 50 | 4 | - | 90 |
| 9 | 1/2.2 | MeOH | 50 | 4 | - | 99 |
| Silatranes | Yield, % | M.p., °C |
|---|---|---|
| 2a | 94 | 109–110 |
| 2b | 91 | 122–123 |
| 3a | 93 | 98–100 |
| 3b | 92 | 103–104 |
| 4a | 92 | 99–101 |
| 4b | 93 | 104–106 |
| 5a | 73 | 111–112 |
| 5b | 69 | 114–115 |
| 6a | 91 | 118–120 |
| 6b | 91 | 129–131 |
| 7a * | 66 | 133–135 |
| Bond lengths, Å | 2a | 2b * |
|---|---|---|
| Si1–N1 | 2.203 | 2.181 |
| Si1–C1 | 1.875 | 1.888 |
| Si1–Ox | 1.663–1.669 | 1.677–1.678 |
| Bond angles, ° | ||
| C1–Si1–Ox | 97.1–98.0 | 97.0–97.7 |
| Ox–Si–Ox’ | 117.9–118.5 | 117.3–119.5 |
| N1–Si1–Ox | 81.9–82.6 | 82.3–83.0 |
| Si1–Ox–Cx1 | 122.6–123.4 | 121.8–123.6 |
| Ox–Cx1–Cx2 | 108.3–109.3 | 107.9–109.3 |
| N1–Cx2–Cx1 | 105.9–106.1 | 105.4–106.3 |
| Silatrane | L. monocyt. | S. aureus | Y. pseudotuber. | Y. enterocolit. | Y. pestis |
|---|---|---|---|---|---|
| SI, % | SI, % | SI, % | SI, % | SI, % | |
| 2a | – | 30–74 | 10–40 | 11–30 | 18–20 |
| 2b | – | 32–76 | 13–25 | – | 12–18 |
| 4a | 32–46 | 15–59 | 14–26 | 16–24 | 10–20 |
| 5a | – | 11–37 | – | 16–24 | 10–15 |
| 7a | – | 30–63 | – | 11–13 | 18 |
| Compound | 2a | 2b |
|---|---|---|
| Empirical formula | C12H23N3O3Si | C15H26N4O3Si |
| Formula weight, g/mol | 285.42 | 338.49 |
| Temperature, K | 150(2) | 150(2) |
| Radiation | MoKα (λ = 0.71073) | MoKα (λ = 0.71073) |
| Crystal system | Monoclinic | Orthorhombic |
| Space group | P21/c | Pbca |
| a, Å/α, ° | 11.1251(3)/90 | 12.2082(3)/90 |
| b, Å/β, ° | 10.2541(2)/110.5460(10) | 13.5352(4)/90 |
| c, Å/γ, ° | 13.4672(3)/90 | 21.5488(6)/90 |
| Volume, Å3 | 1438.59(6) | 3560.73(17) |
| Z | 4 | 8 |
| ρcalc, g/cm3 | 1.318 | 1.263 |
| μ, mm−1 | 0.172 | 0.152 |
| F(000) | 616.0 | 1456.0 |
| Crystal size, mm3 | 0.17 × 0.12 × 0.025 | 0.34 × 0.33 × 0.29 |
| 2θ range, ° | 3.9–63.1 | 4.9–63.0 |
| Index ranges | −14 ≤ h ≤ 16, −11 ≤ k ≤ 15, −19 ≤ l ≤ 18 | −17 ≤ h ≤ 17, −18 ≤ k ≤ 19, −31 ≤ l ≤ 31 |
| Reflections collected/independent | 14,251/4769 | 89,579/5916 |
| Rint/Rσ | 0.0342/0.0411 | 0.0351/0.0139 |
| Data/restraints/parameters | 4769/0/175 | 5916/45/237 |
| Goodness-of-fit on F2 | 1.036 | 1.036 |
| Final R1/wR2 indexes ≥ 2σ (I) all data | 0.0404/0.0945 0.0564/0.1024 | 0.0309/0.0859 0.0354/0.0890 |
| Largest diff. peak/hole, e/Å3 | 0.41/−0.32 | 0.35/−0.26 |
Disclaimer/Publisher’s Note: The statements, opinions and data contained in all publications are solely those of the individual author(s) and contributor(s) and not of MDPI and/or the editor(s). MDPI and/or the editor(s) disclaim responsibility for any injury to people or property resulting from any ideas, methods, instructions or products referred to in the content. |
© 2023 by the authors. Licensee MDPI, Basel, Switzerland. This article is an open access article distributed under the terms and conditions of the Creative Commons Attribution (CC BY) license (https://creativecommons.org/licenses/by/4.0/).
Share and Cite
Adamovich, S.N.; Ushakov, I.A.; Oborina, E.N.; Lukyanova, S.V.; Komarov, V.Y. New 3-Aminopropylsilatrane Derivatives: Synthesis, Structure, Properties, and Biological Activity. Int. J. Mol. Sci. 2023, 24, 9965. https://doi.org/10.3390/ijms24129965
Adamovich SN, Ushakov IA, Oborina EN, Lukyanova SV, Komarov VY. New 3-Aminopropylsilatrane Derivatives: Synthesis, Structure, Properties, and Biological Activity. International Journal of Molecular Sciences. 2023; 24(12):9965. https://doi.org/10.3390/ijms24129965
Chicago/Turabian StyleAdamovich, Sergey N., Igor A. Ushakov, Elizaveta N. Oborina, Svetlana V. Lukyanova, and Vladislav Y. Komarov. 2023. "New 3-Aminopropylsilatrane Derivatives: Synthesis, Structure, Properties, and Biological Activity" International Journal of Molecular Sciences 24, no. 12: 9965. https://doi.org/10.3390/ijms24129965
APA StyleAdamovich, S. N., Ushakov, I. A., Oborina, E. N., Lukyanova, S. V., & Komarov, V. Y. (2023). New 3-Aminopropylsilatrane Derivatives: Synthesis, Structure, Properties, and Biological Activity. International Journal of Molecular Sciences, 24(12), 9965. https://doi.org/10.3390/ijms24129965
